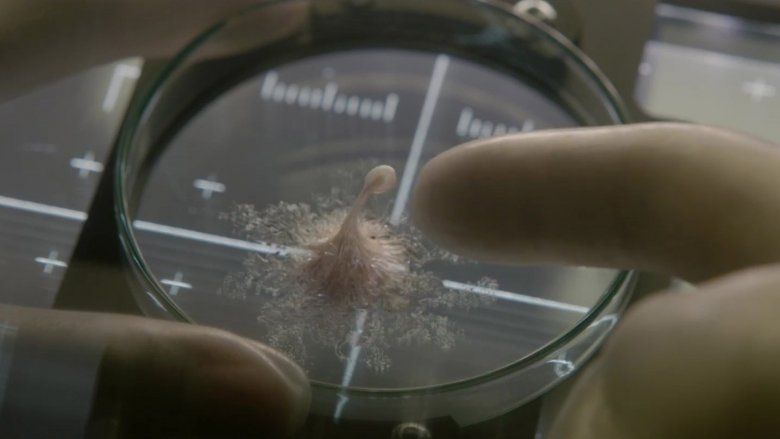

Film: Hayat / Life
Vizyon Tarihi: 24 Mart 2017
Yönetmen: Daniel Espinosa
Oyuncular: Jake Gyllenhaal, Rebecca Ferguson, Ryan Reynolds
Bilim kurgu klasiği “Alien”a benzeyen filmlere göz atıyoruz.
Film: Hayat / Life
Vizyon Tarihi: 24 Mart 2017
Yönetmen: Daniel Espinosa
Oyuncular: Jake Gyllenhaal, Rebecca Ferguson, Ryan Reynolds